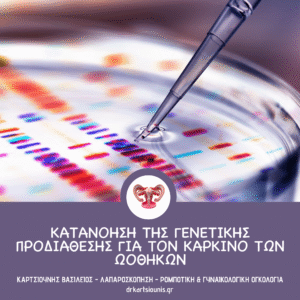

Η χειρουργική επέμβαση αποτελεί βασικό πυλώνα στη θεραπεία των περισσότερων μορφών γυναικολογικού καρκίνου. Οι σύγχρονες εξελίξεις έχουν καταστήσει τις επεμβάσεις πιο στοχευμένες, λιγότερο επεμβατικές και πιο αποτελεσματικές.
Ανάλογα με τον τύπο και το στάδιο της νόσου, η χειρουργική θεραπεία μπορεί να εφαρμοστεί:
• ως κύρια θεραπεία
• ή σε συνδυασμό με χημειοθεραπεία και ακτινοθεραπεία
Οι συχνότεροι γυναικολογικοί καρκίνοι που αντιμετωπίζονται χειρουργικά είναι:
• καρκίνος τραχήλου μήτρας
• καρκίνος ενδομητρίου
• καρκίνος ωοθηκών
• σπανιότερα, σαρκώματα μήτρας και καρκίνος κόλπου
________________________________________
Βασικές χειρουργικές μέθοδοι
Η επιλογή της κατάλληλης επέμβασης εξατομικεύεται, με βάση:
• το στάδιο της νόσου
• την έκταση της διασποράς
• την ηλικία και τις ανάγκες της ασθενούς
________________________________________
Κωνοειδής εκτομή (Conization)
Η κωνοειδής εκτομή είναι μια ελάχιστα επεμβατική τεχνική που εφαρμόζεται στον τράχηλο της μήτρας.
Χρησιμοποιείται:
• σε προκαρκινικές αλλοιώσεις
• σε πολύ πρώιμο καρκίνο
👉 Πλεονέκτημα: διατηρείται η γονιμότητα
________________________________________
Ριζική τραχηλεκτομή
Εφαρμόζεται σε επιλεγμένες γυναίκες με πρώιμο καρκίνο τραχήλου που επιθυμούν τεκνοποίηση.
Κατά την επέμβαση:
• αφαιρείται ο τράχηλος
• διατηρείται η μήτρα
👉 Επιτρέπει μελλοντική εγκυμοσύνη υπό προϋποθέσεις
________________________________________
Υστερεκτομή
Η υστερεκτομή αποτελεί βασική θεραπεία σε:
• καρκίνο ενδομητρίου
• καρκίνο τραχήλου
Τύποι υστερεκτομής:
• Απλή (ολική): αφαίρεση μήτρας και τραχήλου
• Ριζική: αφαίρεση μήτρας, τραχήλου και παραμητρίων + λεμφαδένες
• Με σαλπιγγο-ωοθηκεκτομή: αφαίρεση και ωοθηκών/σαλπίγγων όπου ενδείκνυται
________________________________________
Λεμφαδενικός καθαρισμός
Αποτελεί βασικό μέρος της σταδιοποίησης.
Σήμερα εφαρμόζεται ευρέως η τεχνική:
👉 λεμφαδένα-φρουρού (sentinel node)
Πλεονεκτήματα:
• λιγότερες επιπλοκές
• μικρότερος κίνδυνος λεμφοιδήματος
________________________________________
Κυτταρομειωτική χειρουργική (debulking)
Χρησιμοποιείται κυρίως στον καρκίνο των ωοθηκών.
Στόχος:
👉 η αφαίρεση όσο το δυνατόν μεγαλύτερου όγκου νόσου
Συχνά συνδυάζεται με χημειοθεραπεία για βέλτιστο αποτέλεσμα.
________________________________________
Ελάχιστα επεμβατικές τεχνικές
Η σύγχρονη χειρουργική ογκολογία δίνει έμφαση σε λιγότερο τραυματικές μεθόδους.
________________________________________
Λαπαροσκοπική χειρουργική
Πραγματοποιείται μέσω μικρών τομών με χρήση κάμερας.
Πλεονεκτήματα:
• μικρότερος πόνος
• λιγότερη απώλεια αίματος
• ταχύτερη ανάρρωση
________________________________________
Ρομποτική χειρουργική
Η πιο εξελιγμένη μορφή ελάχιστα επεμβατικής χειρουργικής.
Προσφέρει:
• υψηλή ακρίβεια κινήσεων
• καλύτερο χειρισμό δύσκολων ανατομικών περιοχών
Εφαρμόζεται κυρίως σε:
• καρκίνο ενδομητρίου
• καρκίνο τραχήλου
________________________________________
Ανάρρωση μετά το χειρουργείο
Η ανάρρωση εξαρτάται από το είδος της επέμβασης.
• Ελάχιστα επεμβατικές τεχνικές → ταχύτερη επιστροφή στην καθημερινότητα
• Εκτεταμένες επεμβάσεις → μεγαλύτερος χρόνος αποκατάστασης
Συνήθως συστήνεται:
• αποφυγή έντονης δραστηριότητας για λίγες εβδομάδες
• τακτική ιατρική παρακολούθηση
• σωστή διατροφή και ενυδάτωση
• ψυχολογική υποστήριξη όπου χρειάζεται
________________________________________
Συμπέρασμα
Η χειρουργική στη γυναικολογική ογκολογία έχει εξελιχθεί σημαντικά, προσφέροντας ασφαλείς και αποτελεσματικές θεραπευτικές επιλογές.
Η σωστή προσέγγιση είναι πάντα εξατομικευμένη και βασίζεται στα χαρακτηριστικά κάθε ασθενούς.
👉 Ο Δρ. Καρτσιούνης εφαρμόζει σύγχρονες, ελάχιστα επεμβατικές και εξατομικευμένες τεχνικές, με στόχο τη βέλτιστη θεραπεία και τη διατήρηση της ποιότητας ζωής.